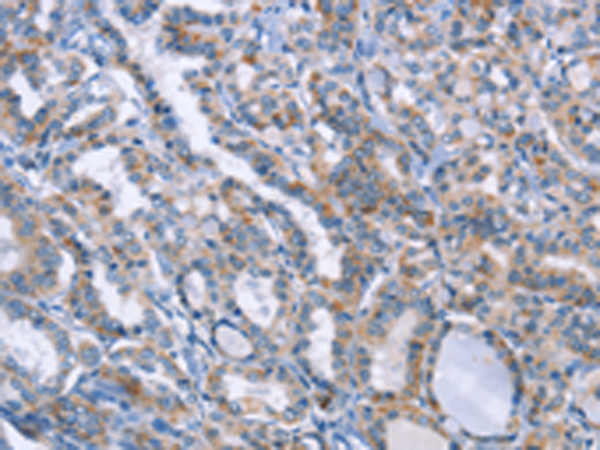
一抗

|
Background: |
This gene is a member of the leucine-rich repeat kinase family and encodes a protein with an ankryin repeat region, a leucine-rich repeat (LRR) domain, a kinase domain, a DFG-like motif, a RAS domain, a GTPase domain, a MLK-like domain, and a WD40 domain. The protein is present largely in the cytoplasm but also associates with the mitochondrial outer membrane. Mutations in this gene have been associated with Parkinson disease-8. |
|
Applications: |
ELISA, IHC |
|
Name of antibody: |
LRRK2 |
|
Immunogen: |
Fusion protein of human LRRK2 |
|
Full name: |
leucine-rich repeat kinase 2 |
|
Synonyms: |
PARK8; RIPK7; ROCO2; AURA17; DARDARIN |
|
SwissProt: |
Q5S007 |
|
ELISA Recommended dilution: |
2000-5000 |
|
IHC positive control: |
Human thyroid cancer |
|
IHC Recommend dilution: |
25-100 |

 購物車
購物車 幫助
幫助
 021-54845833/15800441009
021-54845833/15800441009